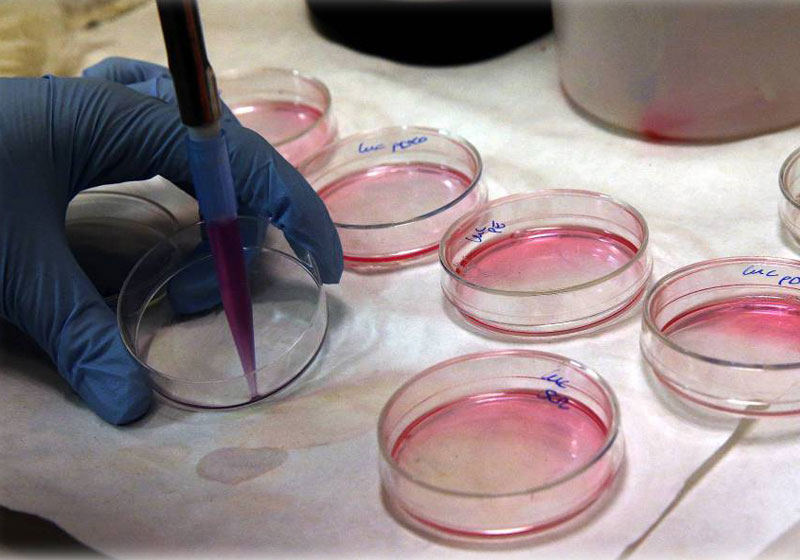
Cultivo de células em laboratório Foto: ULY MARTIN

EUA aprovam 1ª terapia genética contra câncer
Esperança contra a Leucemia. Os EUA aprovaram a primeira terapia genética de uso comercial para o tratamento de câncer.
A FDA, agência que regulamenta o uso de medicamentos, deu sinal verde para a aplicação do novo tratamento que demonstrou ser eficiente em crianças ou jovens de até 25 anos com leucemia linfoide aguda, que não reagem aos tratamentos normais.
Em um teste realizado em 12 países, 83% dos participantes viram sua doença perder intensidade.
Um ano depois, dois terços estavam livres do câncer.
Kymriah
O tratamento, desenvolvido pela Novartis e batizado de Kymriah, baseia-se na técnica CART.
A terapia começa com a extração de linfócitos do paciente, os quais serão depois levados a um laboratório da empresa farmacêutica.
Lá, com o uso de vírus da aids mutilados, os linfócitos são alterados geneticamente para melhorá-los e transmitir a eles capacidade para atacar as células tumorais, que normalmente escapariam de sua ação.
Por fim, essas células imunes aperfeiçoadas são injetadas no paciente, na expectativa de que realizem o seu trabalho.
Efeitos colaterais diminuiram
Esse tipo de glóbulo branco melhorado já provocou efeitos colaterais graves no passado.
A morte de cinco pacientes por inflamação do cérebro levou a empresa Juno Therapeutics, dos EUA, a suspender um teste que utilizava uma técnica semelhante.
Nos novos estudos a Novartis não registrou esse tipo de problema.
Tratamento caro
Segundo o jornal The Washington Post publicou há algumas semanas, embora a Novartis não tenha revelado os custos de sua terapia contra a leucemia, os analistas estimam que a injeção única custará entre 250.000 euros e 500.000 euros (925.000 reais e 1,8 milhão de reais).
A empresa afirma que irá trabalhar para fazer com que o preço do medicamento “se baseie nos resultados clínicos atingidos, que eliminariam as deficiências do sistema e saúde”.
Ela estaria fazendo uma negociação para que o tratamento só seja pago quando os pacientes reagirem em até um mês desde a sua aplicação.
20 anos de testes
A aprovação é um novo passo que aproxima mais a terapia genética da prática médica comum.
A ideia vem sendo testada há mais de duas décadas, mas parece que finalmente começam a ser superadas as dificuldades técnicas para encontrar os vírus apropriados para promover as alterações genéticas nas células humanas sem causar efeitos colaterais muito graves.
No começo deste século, o uso de retrovírus como vetores para os novos genes provocou vários casos de leucemia. Com as novas técnicas, que usam lentivirus, a segurança é muito maior.
Com informações do ElPaís

Butantan amplia para 10 cidades a aplicação da vacina contra chikungunya
Polilaminina será distribuída pelo SUS, após aprovação da Anvisa, diz dra. Tatiana Sampaio
Repórter cadeirante entrevista Dra. Tatiana Sampaio sobre a polilaminina e abraço emociona; vídeo
Dra. Tatiana da Polilaminina estará no Roda Viva, na estreia de Ernesto Paglia, nesta segunda-feira
Paraplégico fica de pé pela primeira vez 1 mês após injeção da polilaminina; vídeo
Vacina contra dependência de crack e cocaína: Brasil vai começar testes em humanos
Bombeira se aposenta, ganha homenagem e se emociona: “hora de cuidar de mim”; vídeo
Começa Feirão Limpa Nome; veja onde negociar dívidas com 99% de desconto
20 anos sem Gisberta, a brasileira que virou música e obrigou Portugal a combater a transfobia
Criança interrompe missa com gatinho e pede para o padre abençoar o felino; vídeo
Autista, filha de doméstica e pai analfabeto, é aprovada em Medicina: “quebra de ciclo histórico”
Desconhecidos recolhem refrigerantes derramados na pista, devolvem ao motorista e vídeo bate 7 milhões